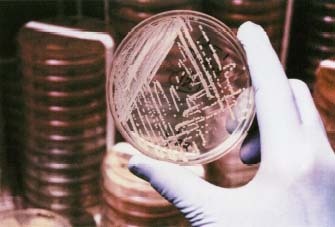

Blog Archive
A collection of 104 posts from the Thomlex blog (2006–2013), preserved from the Wayback Machine.
-
 May 06, 2006This coming Saturday (May 13, 2006), there will be a Summit on the Singularity at Stanford University. If you're in the neighborhood, you want to be there. Everybody who's anybody on the subject will be there, including Ray Kurzweil, Eric Drexler, Douglas R. Hofstadter, Steve Jurvetson, and others....
May 06, 2006This coming Saturday (May 13, 2006), there will be a Summit on the Singularity at Stanford University. If you're in the neighborhood, you want to be there. Everybody who's anybody on the subject will be there, including Ray Kurzweil, Eric Drexler, Douglas R. Hofstadter, Steve Jurvetson, and others.... -
 May 04, 2006Michael Anissimov wrote this great article on Transhumanism. If you're not familiar with the concept, it is that the technology all around us is our next evolutionary step. Today, we think of computers and technologies as things around us, but they'll soon be part of us, and then replace us, much...
May 04, 2006Michael Anissimov wrote this great article on Transhumanism. If you're not familiar with the concept, it is that the technology all around us is our next evolutionary step. Today, we think of computers and technologies as things around us, but they'll soon be part of us, and then replace us, much... -
May 03, 2006The Department of Defense's research arm, the Defense Advance Research Project Agency (DARPA), has announced their latest challenge: build a robotic car that can traverse through urban settings for 60 miles in 6 hours. The challenge is designed to encourage research for the development of...
-
 April 30, 2006For your amusement, I present my sixth grade science fair project. This would be from 1976. This gadget will add two binary numbers together. (You can also subtract by making one of the numbers negative). I called it BASC-1 (Binary Adding/Subtracting Calculator). In this picture, you can see it...
April 30, 2006For your amusement, I present my sixth grade science fair project. This would be from 1976. This gadget will add two binary numbers together. (You can also subtract by making one of the numbers negative). I called it BASC-1 (Binary Adding/Subtracting Calculator). In this picture, you can see it... -
 April 30, 2006RFID is coming in a big way. If you aren't familiar with the term, RFID is a way to mark objects by applying a "tag" to them and identifing them using radio technology. The tags contain a unique identification number, and a reader can send them a signal that will cause them to transmit that id back...
April 30, 2006RFID is coming in a big way. If you aren't familiar with the term, RFID is a way to mark objects by applying a "tag" to them and identifing them using radio technology. The tags contain a unique identification number, and a reader can send them a signal that will cause them to transmit that id back... -
 April 30, 2006Alexander Van de Rostyne built Pixelito, a 6.9 gram remote-control helicopter. Pixelito is fully functional, with 4 channels of control via infra red. It has no servos and no swashplate. The swashplate is the mechanism that allows the spinning blades to be tilted forward or back or side to side,...
April 30, 2006Alexander Van de Rostyne built Pixelito, a 6.9 gram remote-control helicopter. Pixelito is fully functional, with 4 channels of control via infra red. It has no servos and no swashplate. The swashplate is the mechanism that allows the spinning blades to be tilted forward or back or side to side,... -
 April 28, 2006Another shameless plug for Bill's art. This one's called Warren 5. I made it shortly after the great Warren Zevon passed away, though frankly I don't see any connection. Link
April 28, 2006Another shameless plug for Bill's art. This one's called Warren 5. I made it shortly after the great Warren Zevon passed away, though frankly I don't see any connection. Link -
 April 28, 2006Runbot is a two-legged robot that walks. fast. It's one foot tall and moves 3.5 leg-lengths per second, which is twice as fast as it's closest competitor, Spring Flamingo (developed at MIT). If Runbot were a human, it would be walking 10 feet per second. Runbot was developed at the University of...
April 28, 2006Runbot is a two-legged robot that walks. fast. It's one foot tall and moves 3.5 leg-lengths per second, which is twice as fast as it's closest competitor, Spring Flamingo (developed at MIT). If Runbot were a human, it would be walking 10 feet per second. Runbot was developed at the University of... -
 April 26, 2006Quaketronics is two brothers who make an inexpensive ($99) rig for shooting your own high-speed photographs. I met them at the Maker's Faire this last weekend (which was extremely cool, btw). This picture is of my son Alex popping a balloon. Link
April 26, 2006Quaketronics is two brothers who make an inexpensive ($99) rig for shooting your own high-speed photographs. I met them at the Maker's Faire this last weekend (which was extremely cool, btw). This picture is of my son Alex popping a balloon. Link -
 April 24, 2006Completely Sequenced Genomes Table of genomes which have been completely sequenced. This is updated regularly and is well-organized. Has lots of cool, relevant links.
April 24, 2006Completely Sequenced Genomes Table of genomes which have been completely sequenced. This is updated regularly and is well-organized. Has lots of cool, relevant links. -
 April 22, 2006This image in sand was made by a hanging pendulum that shook during a 6.8 earthquake which shook for half a minute. Link
April 22, 2006This image in sand was made by a hanging pendulum that shook during a 6.8 earthquake which shook for half a minute. Link -
 April 20, 2006Professor Howie Choset of Carnegie Mellon University and his team have built this robotic snake. More advanced versions could crawl through collapsed buildings to locate survivors. The remote-controlled machines are designed to carry cameras and electronic sensors. The current version is already...
April 20, 2006Professor Howie Choset of Carnegie Mellon University and his team have built this robotic snake. More advanced versions could crawl through collapsed buildings to locate survivors. The remote-controlled machines are designed to carry cameras and electronic sensors. The current version is already... -
 April 19, 2006Raffaello D'Andrea built this robotic chair that falls completely apart (the legs and back detach and fall away), then crawls around and puts itself back together. Go to the link and check out the video. Not to be confused with the walking chair. Link
April 19, 2006Raffaello D'Andrea built this robotic chair that falls completely apart (the legs and back detach and fall away), then crawls around and puts itself back together. Go to the link and check out the video. Not to be confused with the walking chair. Link -
 April 18, 2006Fascinating collection of maps of the United States, showing per county races, religions, income, politics, etc. from various sources, especially the U.S. Census data. This graph shows racial ancestery. Link
April 18, 2006Fascinating collection of maps of the United States, showing per county races, religions, income, politics, etc. from various sources, especially the U.S. Census data. This graph shows racial ancestery. Link -
 April 18, 2006The picture, taken near Ajo, Arizona is a multiple exposure, each shot taken ten days apart, at 8:30 AM for a year. The sun's seasonal shift forms this figure 8, known as the analemma. Because of this effect, sundials can run ahead of clock time by as much as 16 mins 33 secs or fall behind by as...
April 18, 2006The picture, taken near Ajo, Arizona is a multiple exposure, each shot taken ten days apart, at 8:30 AM for a year. The sun's seasonal shift forms this figure 8, known as the analemma. Because of this effect, sundials can run ahead of clock time by as much as 16 mins 33 secs or fall behind by as... -
 April 16, 2006Wristwatch sales are on the decline amongst young people. What's the purpose, when every cell phone and MP3 player tells the time? Even Fossil, the top brand for teens, acknowledged an 18.6% decline in wholesale U.S. sales of its namesake brand. Link
April 16, 2006Wristwatch sales are on the decline amongst young people. What's the purpose, when every cell phone and MP3 player tells the time? Even Fossil, the top brand for teens, acknowledged an 18.6% decline in wholesale U.S. sales of its namesake brand. Link -
 April 15, 2006Anti-matter is the strongest fuel known. To send humans to Mars would require tons of chemical fuel, where if anti-matter were used, just tens of milligrams of the stuff would be required. That's about 1/100th the weight of an M&M. The three big challenges are producing it, containing it during...
April 15, 2006Anti-matter is the strongest fuel known. To send humans to Mars would require tons of chemical fuel, where if anti-matter were used, just tens of milligrams of the stuff would be required. That's about 1/100th the weight of an M&M. The three big challenges are producing it, containing it during... -
 April 12, 2006Bummer! I saw George's Vlosich III's amazing Etch-A-Sketch art on several blogs and was planning to make a robot to control an Etch-A-Sketch. I'd even spent some time thinking about the drawing algorithm. Looks like Scott Ferguson is way ahead of me and has already done this. His setup is very...
April 12, 2006Bummer! I saw George's Vlosich III's amazing Etch-A-Sketch art on several blogs and was planning to make a robot to control an Etch-A-Sketch. I'd even spent some time thinking about the drawing algorithm. Looks like Scott Ferguson is way ahead of me and has already done this. His setup is very... -
 April 12, 2006Joel Cooper created these masks, each from a single sheet of paper. The technique is called an "origami tessellation", because the original intent of it was to create tessellations, i.e. interlocking polygons and such. Very impressive. Link
April 12, 2006Joel Cooper created these masks, each from a single sheet of paper. The technique is called an "origami tessellation", because the original intent of it was to create tessellations, i.e. interlocking polygons and such. Very impressive. Link -
 April 12, 2006Last year, chemists were able to build a car from a single-molecule. Now, chemists at Rice University have built the first motorized version of their nanocar. The nanocar is powered by light. Its motor is a molecular framework that was developed by Ben L. Feringa and was modified so that it would...
April 12, 2006Last year, chemists were able to build a car from a single-molecule. Now, chemists at Rice University have built the first motorized version of their nanocar. The nanocar is powered by light. Its motor is a molecular framework that was developed by Ben L. Feringa and was modified so that it would... -
 April 12, 2006Gary J. Gorbsky of the Oklahoma Medical Research Foundation, has found a way to reverse the process of cell division. This discovery shows that events in the cell cycle which have long been assumed to be irreversible, may be. The discovery could have an important impact on the treatment of cancer,...
April 12, 2006Gary J. Gorbsky of the Oklahoma Medical Research Foundation, has found a way to reverse the process of cell division. This discovery shows that events in the cell cycle which have long been assumed to be irreversible, may be. The discovery could have an important impact on the treatment of cancer,... -
 April 12, 2006Another shameless plug for Bill's art. This one is called Globes 2. Link
April 12, 2006Another shameless plug for Bill's art. This one is called Globes 2. Link -
 April 11, 2006Make various polyhedra from paper. Link
April 11, 2006Make various polyhedra from paper. Link -
 April 11, 2006The Swiss Federal Institute of Technology has developed an ultralight robotic aircraft that mimics the navigational abilities of a fly. The plane is completely autonomous, weighs 10 grams and has a 14 inch wingspan. It is designed to fly indoors, which is difficult because of the many potential...
April 11, 2006The Swiss Federal Institute of Technology has developed an ultralight robotic aircraft that mimics the navigational abilities of a fly. The plane is completely autonomous, weighs 10 grams and has a 14 inch wingspan. It is designed to fly indoors, which is difficult because of the many potential... -
 April 11, 2006How to extract DNA (and RNA) from anything living using household materials. Link
April 11, 2006How to extract DNA (and RNA) from anything living using household materials. Link -
April 10, 200619th century vampire killing kit. The 20 pound box contains a wooden hammer, four stakes, a prayer book, a crucifix, a knife and eight bottles containing holy soil, holy water, anointing oil, holy incense, garlic, red serum, blue serum and secret potion. Believed to be made by a romanian monk from...
-
 April 08, 2006Yet another shameless plug for Bill's art. This one's called Bleak. Link
April 08, 2006Yet another shameless plug for Bill's art. This one's called Bleak. Link -
 April 08, 2006Scientists at Oregon State University have proposed that supposedly-stable DNA bases can be pushed into a "dark state" where they are highly vulnerable to damage from ultraviolet radiation. The idea challenges some of the most basic concepts of modern biochemistry. Only tangentially-related, but...
April 08, 2006Scientists at Oregon State University have proposed that supposedly-stable DNA bases can be pushed into a "dark state" where they are highly vulnerable to damage from ultraviolet radiation. The idea challenges some of the most basic concepts of modern biochemistry. Only tangentially-related, but... -
 April 08, 2006Build your own MP3 player that fits inside an Altoids gum tin. Charges its internal battery over USB and mounts itself as a drive, runs for 12+ hours on a full charge and looks very cool. Full instructions here, including schematic (they'll post source code soon), or they can build it for you. Link
April 08, 2006Build your own MP3 player that fits inside an Altoids gum tin. Charges its internal battery over USB and mounts itself as a drive, runs for 12+ hours on a full charge and looks very cool. Full instructions here, including schematic (they'll post source code soon), or they can build it for you. Link -
 April 07, 2006If you have $7,000 and 250 hours, you can build your own airplane. The Affordaplane has a wingspan of 27.5 feet, can cruise at 60 to 65 mph and can carry a pilot up to 250 pounds and 6'3". Plans can be had for $24.95. Link
April 07, 2006If you have $7,000 and 250 hours, you can build your own airplane. The Affordaplane has a wingspan of 27.5 feet, can cruise at 60 to 65 mph and can carry a pilot up to 250 pounds and 6'3". Plans can be had for $24.95. Link -
 April 07, 2006MIT scientists have manipulated genes within viruses, coaxing them to grow and self-assemble "nanowire" structures. These structures can then be used to make very thin lithium-ion batteries. The batteries that could be built using this technology could be the size of a grain of rice. Link
April 07, 2006MIT scientists have manipulated genes within viruses, coaxing them to grow and self-assemble "nanowire" structures. These structures can then be used to make very thin lithium-ion batteries. The batteries that could be built using this technology could be the size of a grain of rice. Link -
 April 06, 2006Paleontologists have found a species that fills the evolutionary gap between between fish and land animals. The new species, Tiktaalik roseae, has land animal parts, including a skull, a neck, ribs and parts of the limbs that are similar to four-legged animals, as well as fish-like features such as...
April 06, 2006Paleontologists have found a species that fills the evolutionary gap between between fish and land animals. The new species, Tiktaalik roseae, has land animal parts, including a skull, a neck, ribs and parts of the limbs that are similar to four-legged animals, as well as fish-like features such as... -
 April 06, 2006Mechanical Engineers from Carnegie Mellon University built a robot that can sprint across water. The robot was built to emulate the motions of the basilisk lizard, an iguana that lives in the rain forests of Central and South America. The inventors imagine a day when a more developed version of the...
April 06, 2006Mechanical Engineers from Carnegie Mellon University built a robot that can sprint across water. The robot was built to emulate the motions of the basilisk lizard, an iguana that lives in the rain forests of Central and South America. The inventors imagine a day when a more developed version of the... -
 April 05, 2006Cheri Robertson recently received surgery that allowed her to see, even though previously she was blind. The procedure, performed at the Saint Louis University School of Medicine, is the first to reverse blindness in patients without eyes. A camera on the tip of Robertson's glasses sends signals to...
April 05, 2006Cheri Robertson recently received surgery that allowed her to see, even though previously she was blind. The procedure, performed at the Saint Louis University School of Medicine, is the first to reverse blindness in patients without eyes. A camera on the tip of Robertson's glasses sends signals to... -
 April 05, 2006Researchers at the University of Chicago have created a diode from a single molecule. The diode is only a few tens of atoms in size and 1,000 times smaller than a conventional one. Diodes are critical components within computers and other electronic devices. Nano-Computer Diode from one Molecule
April 05, 2006Researchers at the University of Chicago have created a diode from a single molecule. The diode is only a few tens of atoms in size and 1,000 times smaller than a conventional one. Diodes are critical components within computers and other electronic devices. Nano-Computer Diode from one Molecule -
 April 05, 2006All the statistics you could want on which domain names are registered. All of the two and three letter domains are taken along with most of the 4 letter ones. The most popular length is 11 characters. All of the masculine and feminine first names registered in the U.S. Census Bureau have been...
April 05, 2006All the statistics you could want on which domain names are registered. All of the two and three letter domains are taken along with most of the 4 letter ones. The most popular length is 11 characters. All of the masculine and feminine first names registered in the U.S. Census Bureau have been... -
 April 05, 2006Brien Grieg makes beautiful orreries. An orrery is a model of the solar system that shows the relative positions and motions of the planets and moons. (link from stocktrader). Link
April 05, 2006Brien Grieg makes beautiful orreries. An orrery is a model of the solar system that shows the relative positions and motions of the planets and moons. (link from stocktrader). Link -
 April 05, 2006Retired accountant David Carrick installed a camera in the nest of a pair of eagles while they were away on their annual migration. Last week, the eagles laid two eggs that are expected to hatch by the end of the month. Link
April 05, 2006Retired accountant David Carrick installed a camera in the nest of a pair of eagles while they were away on their annual migration. Last week, the eagles laid two eggs that are expected to hatch by the end of the month. Link -
April 04, 2006Wake Forest University School of Medicine reports the first human recipients of laboratory-grown organs. Children and teenagers received bladders grown from their own cells. Since the engineered bladders were grown from the patients' own cells, there is no risk of rejection. The laboratory-grown...
April 04, 2006Wake Forest University School of Medicine reports the first human recipients of laboratory-grown organs. Children and teenagers received bladders grown from their own cells. Since the engineered bladders were grown from the patients' own cells, there is no risk of rejection. The laboratory-grown... -
 April 04, 2006Ames (Iowa) Laboratory researchers have developed a porous silica nanosphere that can be taken up by a cell and deliver a payload into it on command. The nanospheres are roughly the size of a virus, so they won't trigger an immune response in the body. The spheres have thousands of parallel...
April 04, 2006Ames (Iowa) Laboratory researchers have developed a porous silica nanosphere that can be taken up by a cell and deliver a payload into it on command. The nanospheres are roughly the size of a virus, so they won't trigger an immune response in the body. The spheres have thousands of parallel... -
 April 04, 2006Another shameless promotion for Bill's art. This one is called Intersection. Link
April 04, 2006Another shameless promotion for Bill's art. This one is called Intersection. Link -
 April 04, 2006Knitting machine constructed entirely from Legos. There's a video as well. Link
April 04, 2006Knitting machine constructed entirely from Legos. There's a video as well. Link -
 April 03, 2006Cockroaches make decisions in a democratic fashion and group consultations are done before decisions are made. This was determined in tests where cockroaches were observed as they decided how to organize themselves among multiple shelters. Link
April 03, 2006Cockroaches make decisions in a democratic fashion and group consultations are done before decisions are made. This was determined in tests where cockroaches were observed as they decided how to organize themselves among multiple shelters. Link -
 April 03, 2006Understanding the workings of insect ears could lead to new microphones able to capture and analyse extremely faint sounds. Scientists have been studying the workings of the 'ears' of a locust. These are micrometer-thick membranes with complex and varying structural properties. Link
April 03, 2006Understanding the workings of insect ears could lead to new microphones able to capture and analyse extremely faint sounds. Scientists have been studying the workings of the 'ears' of a locust. These are micrometer-thick membranes with complex and varying structural properties. Link -
 April 01, 2006World Map pops up news items where they're happening. Link
April 01, 2006World Map pops up news items where they're happening. Link -
 April 01, 2006Complete with tapedrive and typewriter. Operates at around 0.12Mhz, has roughly 2K of memory and each tape holds around 360K. It has 200 tubes, compared to hundreds of millions of transistors in a modern PC. The thing that caught my eye about this is the typewriter. It's a Flexowriter by Singer. I...
April 01, 2006Complete with tapedrive and typewriter. Operates at around 0.12Mhz, has roughly 2K of memory and each tape holds around 360K. It has 200 tubes, compared to hundreds of millions of transistors in a modern PC. The thing that caught my eye about this is the typewriter. It's a Flexowriter by Singer. I... -
 April 01, 2006Hector is a robot that spray paints digital art on walls. Link
April 01, 2006Hector is a robot that spray paints digital art on walls. Link -
 April 01, 2006As computers become smaller and smaller, one of the problems is how to control them, when keyboards can't shrink beyond a certain size. Alvaro Cassinelli, Stephane Perrin & Masatoshi Ishikawa have developed a system that uses lasers to track hand gestures to this end. Link
April 01, 2006As computers become smaller and smaller, one of the problems is how to control them, when keyboards can't shrink beyond a certain size. Alvaro Cassinelli, Stephane Perrin & Masatoshi Ishikawa have developed a system that uses lasers to track hand gestures to this end. Link -
 April 01, 2006Pete Bradshaw built this timeline that tracks the pictures (and associated news articles) most emailed in Yahoo mail. Link
April 01, 2006Pete Bradshaw built this timeline that tracks the pictures (and associated news articles) most emailed in Yahoo mail. Link -
 March 29, 2006Simon Greenwold at MIT Media Lab developed a system that tracks virtual 3d objects in real space. A screen/camera combination is used to view an environment. A 3d mouse is used to create 3d blobs in that environment. The system remembers the locations of these blobs and combines them with the real...
March 29, 2006Simon Greenwold at MIT Media Lab developed a system that tracks virtual 3d objects in real space. A screen/camera combination is used to view an environment. A 3d mouse is used to create 3d blobs in that environment. The system remembers the locations of these blobs and combines them with the real... -
 March 28, 2006European scientists have developed a brain implant capable of receiving signals from more than 16,000 mammalian brain cells , and sending messages back to several hundred cells. (Learn more about Brain-Computer Interfaces in my previous post.) This is a dramatic improvement over the previous...
March 28, 2006European scientists have developed a brain implant capable of receiving signals from more than 16,000 mammalian brain cells , and sending messages back to several hundred cells. (Learn more about Brain-Computer Interfaces in my previous post.) This is a dramatic improvement over the previous... -
 March 28, 2006Time for another shameless plug for Bill's art. This one is called Bubbles 3. Link
March 28, 2006Time for another shameless plug for Bill's art. This one is called Bubbles 3. Link -
 March 27, 2006See the world mapped with each country expanded or shrunk based on various criteria. This example shows each country sized to reflect it's relative proportion of the world's population. Other maps on the site show the world population 2,000 years ago, the total children, imports and exports of...
March 27, 2006See the world mapped with each country expanded or shrunk based on various criteria. This example shows each country sized to reflect it's relative proportion of the world's population. Other maps on the site show the world population 2,000 years ago, the total children, imports and exports of... -
 March 27, 2006A series of videos with time dramatically compressed or expanded. Includes slow-motion videos of a blink, a firecracker exploding, a glass breaking and others. Link
March 27, 2006A series of videos with time dramatically compressed or expanded. Includes slow-motion videos of a blink, a firecracker exploding, a glass breaking and others. Link -
 March 27, 2006Connect your midi instrument to your computer and jam with musicians around the world. I built a similar technology almost 20 years ago so a friend and I could jam together through a 1200 baud modem connection. Unfortunately, there was enough delay that it wasn't much more than an interesting...
March 27, 2006Connect your midi instrument to your computer and jam with musicians around the world. I built a similar technology almost 20 years ago so a friend and I could jam together through a 1200 baud modem connection. Unfortunately, there was enough delay that it wasn't much more than an interesting... -
 March 27, 2006David C. Roy builds sculptures that are wound up like a clock, then various pieces spin to make visually-interesting patterns. Link
March 27, 2006David C. Roy builds sculptures that are wound up like a clock, then various pieces spin to make visually-interesting patterns. Link -
 March 27, 2006Tom Rose built an under-water rebreather from inexpensive parts from Home Depot. A rebreather scrubs carbon-dioxide out of air, allowing it's user to re-use the air they breathe out. A rebreather is much lighter than the equivalent weight for a standard scuba setup, and the diver is less...
March 27, 2006Tom Rose built an under-water rebreather from inexpensive parts from Home Depot. A rebreather scrubs carbon-dioxide out of air, allowing it's user to re-use the air they breathe out. A rebreather is much lighter than the equivalent weight for a standard scuba setup, and the diver is less... -
 March 27, 2006James R. Lavoie and Joseph M. Marino of Rite-Solutions set up an internal stock market where employees could buy and sell business ideas. The highest-valued stocks are seriously considered for implementation. The market was begun in January 2005. Mr. Marino, president of Rite-Solutions, says the...
March 27, 2006James R. Lavoie and Joseph M. Marino of Rite-Solutions set up an internal stock market where employees could buy and sell business ideas. The highest-valued stocks are seriously considered for implementation. The market was begun in January 2005. Mr. Marino, president of Rite-Solutions, says the... -
 March 27, 2006This page has links to two sides of a large wall poster that describe metabolic pathways (thumbnail shown here), and cellular & molecular processes. These are the chemical reactions that happen within cells in living things. I.e. this is a flow-chart of life. Wikipedia has a good primer on the...
March 27, 2006This page has links to two sides of a large wall poster that describe metabolic pathways (thumbnail shown here), and cellular & molecular processes. These are the chemical reactions that happen within cells in living things. I.e. this is a flow-chart of life. Wikipedia has a good primer on the... -
 March 23, 2006Another shameless plug for Bill's art. This one seems to be making the rounds on a bunch of other blogs and websites, so I figure I'll put it here too. I took this photograph in the desert in Pakistan about five years ago. It's a bit washed-out; it was hotter than hell at the time. Link
March 23, 2006Another shameless plug for Bill's art. This one seems to be making the rounds on a bunch of other blogs and websites, so I figure I'll put it here too. I took this photograph in the desert in Pakistan about five years ago. It's a bit washed-out; it was hotter than hell at the time. Link -
 March 23, 2006Sven König wrote software that will take a piece of music/video and automatically divide it into 16th beat samples. It will then listen to another sound-source (such as your voice), and find the best match for each sample of your voice in the original group of samples. It does this real-time, and...
March 23, 2006Sven König wrote software that will take a piece of music/video and automatically divide it into 16th beat samples. It will then listen to another sound-source (such as your voice), and find the best match for each sample of your voice in the original group of samples. It does this real-time, and... -
 March 23, 2006A six-year study of more than a million adults ages 30 to 102 suggests that sleep deprivation is not the health risk some claim. Psychiatry professor Daniel Kripke of the University of California at San Diego, who headed the study, suggests that the concept of sleep deprivation is a myth pushed by...
March 23, 2006A six-year study of more than a million adults ages 30 to 102 suggests that sleep deprivation is not the health risk some claim. Psychiatry professor Daniel Kripke of the University of California at San Diego, who headed the study, suggests that the concept of sleep deprivation is a myth pushed by... -
 March 22, 2006This fragment of papyrus is one of the oldest and most complete diagrams from Euclid's Elements of Geometry. It was found among the remarkable rubbish piles of Oxyrhynchus in 1896-97 and is now located at the University of Pennsylvania. The site has detail on the meaning of the papyrus. Link
March 22, 2006This fragment of papyrus is one of the oldest and most complete diagrams from Euclid's Elements of Geometry. It was found among the remarkable rubbish piles of Oxyrhynchus in 1896-97 and is now located at the University of Pennsylvania. The site has detail on the meaning of the papyrus. Link -
 March 22, 2006Aerogel is the lightest and lowest-density solid known to exist; it weighs only three times that of air. It holds 15 entries in the Guinness Book of World Records, including best insulator. It is 99.8% air, yet is incredibly strong structurally, and can support thousands of times its own weight....
March 22, 2006Aerogel is the lightest and lowest-density solid known to exist; it weighs only three times that of air. It holds 15 entries in the Guinness Book of World Records, including best insulator. It is 99.8% air, yet is incredibly strong structurally, and can support thousands of times its own weight.... -
 March 22, 2006If you don't know, MIT makes much of their course materials available online for free. There are large gaps in many areas, but in general it's very good. I've "taken" a few of the classes in biology and artificial intelligence, and was very impressed. The entire curriculum is covered, from...
March 22, 2006If you don't know, MIT makes much of their course materials available online for free. There are large gaps in many areas, but in general it's very good. I've "taken" a few of the classes in biology and artificial intelligence, and was very impressed. The entire curriculum is covered, from... -
 March 22, 2006Great nature pictures shot by Q. Tuan Luong. This one is of the Delicate Arch in Arches National Park. Link
March 22, 2006Great nature pictures shot by Q. Tuan Luong. This one is of the Delicate Arch in Arches National Park. Link -
 March 22, 2006Stages of human development. View details and pictures of growth from single cell to baby. Link
March 22, 2006Stages of human development. View details and pictures of growth from single cell to baby. Link -
 March 21, 2006John Kyrk built this very cool animation of the evolution of the universe. Move a slider from the Big Bang forward through present times and see various stages of development. Link
March 21, 2006John Kyrk built this very cool animation of the evolution of the universe. Move a slider from the Big Bang forward through present times and see various stages of development. Link -
 March 21, 2006A paperclip will float on water due to surface tension. This picture is photographed through a grill, and the deformation of the water can be seen. Link
March 21, 2006A paperclip will float on water due to surface tension. This picture is photographed through a grill, and the deformation of the water can be seen. Link -
 March 21, 2006Great photography by Abelardo Morell, including this picture of Laboratory Glass (link from Miriam87). Link
March 21, 2006Great photography by Abelardo Morell, including this picture of Laboratory Glass (link from Miriam87). Link -
 March 19, 2006Build circuitry to put LED images on your bicycle wheels. Here pacman chases his ghostly friend. Link
March 19, 2006Build circuitry to put LED images on your bicycle wheels. Here pacman chases his ghostly friend. Link -
 March 19, 2006Stay in Sweden in a hotel built of Ice and Snow. A new hotel is built each winter. Price around $260/night. Link
March 19, 2006Stay in Sweden in a hotel built of Ice and Snow. A new hotel is built each winter. Price around $260/night. Link -
 March 19, 2006Giant scuplture made entirely of eggs. (Link from sadboy). Link
March 19, 2006Giant scuplture made entirely of eggs. (Link from sadboy). Link -
 March 19, 2006Go is one of my favorite board games. It's very well-known in China, Japan and Korea, but not as much so in the west. One of the things that I find particularly appealing about it is that the rules are extremely simple (you can learn to play in a half-hour), yet the number of possible positions is...
March 19, 2006Go is one of my favorite board games. It's very well-known in China, Japan and Korea, but not as much so in the west. One of the things that I find particularly appealing about it is that the rules are extremely simple (you can learn to play in a half-hour), yet the number of possible positions is... -
 March 18, 2006Scientists have collected new evidence of the events in the first trillionth of a second of the universe. The evidence supports the "inflation" scenario, where the universe suddenly grew from submicroscopic to astronmical. Scientists collected this data over 3 years from the Wilkinson Microwave...
March 18, 2006Scientists have collected new evidence of the events in the first trillionth of a second of the universe. The evidence supports the "inflation" scenario, where the universe suddenly grew from submicroscopic to astronmical. Scientists collected this data over 3 years from the Wilkinson Microwave... -
 March 18, 2006Pictures of cars being assembled on an assembly line in Volkswagon's Dresden factory. Link
March 18, 2006Pictures of cars being assembled on an assembly line in Volkswagon's Dresden factory. Link -
 March 18, 2006Mike Walters built his own Mellotron from a set of old Walkmans. The Melotron , invented in the early 60s, was the original sampler, playing one tape loop for each key pressed. Link
March 18, 2006Mike Walters built his own Mellotron from a set of old Walkmans. The Melotron , invented in the early 60s, was the original sampler, playing one tape loop for each key pressed. Link -
 March 17, 2006Nanotechnologists from the University of Texas at Dallas have made artificial muscles that are 100 times stronger than natural muscles. These muscles are fuled by alcohol and hydrogen. These muscles could enable fuel-powered artificial limbs, "smart skins" and morphing structures for air and marine...
March 17, 2006Nanotechnologists from the University of Texas at Dallas have made artificial muscles that are 100 times stronger than natural muscles. These muscles are fuled by alcohol and hydrogen. These muscles could enable fuel-powered artificial limbs, "smart skins" and morphing structures for air and marine... -
 March 17, 2006Photographs of the weather by Roland Vanbrabant. (link from Pumpkin606). Link
March 17, 2006Photographs of the weather by Roland Vanbrabant. (link from Pumpkin606). Link -
 March 16, 2006Scott Haefner suspends a camera from a kite and takes some great aerial photography. Link
March 16, 2006Scott Haefner suspends a camera from a kite and takes some great aerial photography. Link -
 March 16, 2006View the Federal budget graphically. I'm hesitant to post this because it contains large biases, in that it leaves out so-called "mandatory spending" on social security, medicare, and interest (these make up over 60% of the budget last time I checked) and includes a strong political message to act,...
March 16, 2006View the Federal budget graphically. I'm hesitant to post this because it contains large biases, in that it leaves out so-called "mandatory spending" on social security, medicare, and interest (these make up over 60% of the budget last time I checked) and includes a strong political message to act,... -
 March 15, 2006If you haven't heard of brain-computer interfaces before, this Wikipedia article is a good place to start. The concept is connecting human brains to computers. So, you could think about something and effectively google it and know the answer. This sort of technology isn't as crazy as you might...
March 15, 2006If you haven't heard of brain-computer interfaces before, this Wikipedia article is a good place to start. The concept is connecting human brains to computers. So, you could think about something and effectively google it and know the answer. This sort of technology isn't as crazy as you might... -
 March 15, 2006Quickplacer (a high-performance handling robot) is the most rapid in the world. Its high acceleration and braking capacity is 5 times that of a Formula 1 racing car. Link
March 15, 2006Quickplacer (a high-performance handling robot) is the most rapid in the world. Its high acceleration and braking capacity is 5 times that of a Formula 1 racing car. Link -
 March 15, 2006Mazes cut into corn fields. Link
March 15, 2006Mazes cut into corn fields. Link -
 March 15, 2006Paul Rothemund of Caltech can weave any two-dimensional shape or pattern using DNA molecules. This technology, which he calls "DNA origami" could one day be used to construct tiny chemical factories or molecular electronics by attaching proteins and inorganic components to DNA circuit boards. All...
March 15, 2006Paul Rothemund of Caltech can weave any two-dimensional shape or pattern using DNA molecules. This technology, which he calls "DNA origami" could one day be used to construct tiny chemical factories or molecular electronics by attaching proteins and inorganic components to DNA circuit boards. All... -
 March 15, 2006Yet another shameless plug for Bill's art. This one is called Microcosm. Link
March 15, 2006Yet another shameless plug for Bill's art. This one is called Microcosm. Link -
 March 14, 2006This fireplace is fed with water and electricity. The fireplace separates the water into hydrogen and oxygen via electrolysis, then burns the hydrogen (along with some of the oxygen for color), producing heat and water vapor. Yeah, it's far less efficient than just an electric heater, but it's...
March 14, 2006This fireplace is fed with water and electricity. The fireplace separates the water into hydrogen and oxygen via electrolysis, then burns the hydrogen (along with some of the oxygen for color), producing heat and water vapor. Yeah, it's far less efficient than just an electric heater, but it's... -
 March 14, 2006A few posts ago, I linked to an article about micromarketing and the long tail. This link is a blog by the subject of that article and will soon become a book. The graph here shows the percentage of hit (gold, platinum and multi-platinum) records being sold as a percentage of all records being...
March 14, 2006A few posts ago, I linked to an article about micromarketing and the long tail. This link is a blog by the subject of that article and will soon become a book. The graph here shows the percentage of hit (gold, platinum and multi-platinum) records being sold as a percentage of all records being... -
 March 13, 2006Great photographs by Dan Baumbach, including this one of a sunset. Link
March 13, 2006Great photographs by Dan Baumbach, including this one of a sunset. Link -
 March 12, 2006JP Brown built a robot out of Legos that solves the Rubix cube. This one's been around a while, but still mighty cool. Link
March 12, 2006JP Brown built a robot out of Legos that solves the Rubix cube. This one's been around a while, but still mighty cool. Link -
 March 12, 2006This is one of my favorite movies. It's an interview with Robert McNamara, who is a fascinating individual. Born into humble beginnings, he has a professor at Harvard, fought in WWII, moved up the ranks in Ford (where he introduced seat belts into cars) becoming the first CEO who wasn't a member of...
March 12, 2006This is one of my favorite movies. It's an interview with Robert McNamara, who is a fascinating individual. Born into humble beginnings, he has a professor at Harvard, fought in WWII, moved up the ranks in Ford (where he introduced seat belts into cars) becoming the first CEO who wasn't a member of... -
 March 11, 2006Robert P. Crease recently asked physicists to nominate the most beautiful experiments of all time; this is a list of the top ten. This graphic demonstrates an experiment done by Galileo where he rolled a ball down a plane and used a water clock to time it's speed. He discovered that the ball...
March 11, 2006Robert P. Crease recently asked physicists to nominate the most beautiful experiments of all time; this is a list of the top ten. This graphic demonstrates an experiment done by Galileo where he rolled a ball down a plane and used a water clock to time it's speed. He discovered that the ball... -
 March 08, 2006If you haven't heard of the singularity, this link at Wikipedia is a great place to start. The basic concept is that technology is constantly moving faster, and at some point humans won't be able to keep up with it. We'll enter a new era where human brains aren't sufficient to deal with the world,...
March 08, 2006If you haven't heard of the singularity, this link at Wikipedia is a great place to start. The basic concept is that technology is constantly moving faster, and at some point humans won't be able to keep up with it. We'll enter a new era where human brains aren't sufficient to deal with the world,... -
 March 08, 2006John Reeves of Fairbanks, Alaska set up a sprinkler system and pumped water through it, building this enormous ice tower. He's shown in this picture as the spec on the bottom right. He expects it will be 160 to 180 feet tall and weigh 80,000 tons by April when he intends to turn off the water to...
March 08, 2006John Reeves of Fairbanks, Alaska set up a sprinkler system and pumped water through it, building this enormous ice tower. He's shown in this picture as the spec on the bottom right. He expects it will be 160 to 180 feet tall and weigh 80,000 tons by April when he intends to turn off the water to... -
 March 05, 2006Andrew Carol built a difference machine from Legos. The Difference Machine was invented by Charles Babbage, and uses Newton's method of differences to evaluate a polynomial. This lego version can compute 2nd or 3rd order polynomials to 3 or 4 digits. Link
March 05, 2006Andrew Carol built a difference machine from Legos. The Difference Machine was invented by Charles Babbage, and uses Newton's method of differences to evaluate a polynomial. This lego version can compute 2nd or 3rd order polynomials to 3 or 4 digits. Link -
 March 02, 2006Play chess against the computer and see what the computer's thinking. See waves of influence between turns, and while the computer is thinking, see which moves the computer is pondering (as pictured here). It takes forever to make moves and it isn't a very good player (it doesn't know any openings...
March 02, 2006Play chess against the computer and see what the computer's thinking. See waves of influence between turns, and while the computer is thinking, see which moves the computer is pondering (as pictured here). It takes forever to make moves and it isn't a very good player (it doesn't know any openings... -
 February 28, 2006Taiwanese students, unhappy about the limit of one trip to the salad bar at Pizza Hut, seek to maximize their salad investment. Link
February 28, 2006Taiwanese students, unhappy about the limit of one trip to the salad bar at Pizza Hut, seek to maximize their salad investment. Link -
 February 13, 2006X-Ray of a bouquet of roses Link
February 13, 2006X-Ray of a bouquet of roses Link -
 February 13, 2006Two roommates invent various gymnastic challenges they can do in their house. Link
February 13, 2006Two roommates invent various gymnastic challenges they can do in their house. Link -
 February 13, 2006Very cool sand castles. Link
February 13, 2006Very cool sand castles. Link -
 February 13, 2006Amazing original origami by Robert J. Lang. This is a tree-frog, of course. Link
February 13, 2006Amazing original origami by Robert J. Lang. This is a tree-frog, of course. Link -
 February 13, 2006Very cool collection of science and art oriented links Link
February 13, 2006Very cool collection of science and art oriented links Link -
 February 12, 2006Very cool. Dude makes card castles. Link
February 12, 2006Very cool. Dude makes card castles. Link -
February 08, 2006Gotta love bash.org. Super funny. In a nerd way. Contains such gems as: Zybl0re: get upZybl0re: get on upZybl0re: get upZybl0re: get on upphxl|paper: and DANCE * nmp3bot dances :D-< * nmp3bot dances :D|-< * nmp3bot dances :D/-<[SA]Hatful-Of-Hollow: i'm going to become rich and famous after i invent...



